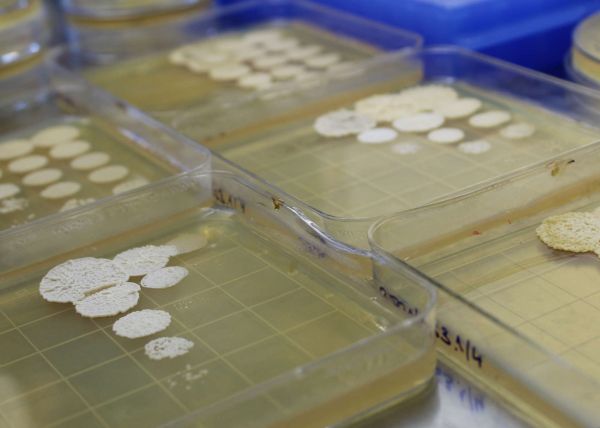

New research shows that when the microbe Ustilago maydis undergoes programmed cell death due, it releases substances that actually help surviving cells recover, grow and reproduce. These substances are more beneficial than nutrients from cells that die through uncontrolled necrosis. Remarkably, surviving cells not only regrow in harsh conditions but also gain a competitive edge. This discovery highlights a surprising survival strategy and opens the door for further studies into how microbial communities rebuild after stress.
The research was conducted within the project GENOVA funded by the Science Fund of the Republic of Serbia through the IDEAS program.
Biomolecules Generated During Programmed Cell Death (PCD) Enhance the Capacity of Proliferating Ustilago maydis Cells to Overcome the Negative Impacts of Non-PCD Necromass
Plant Molecular Biology Group